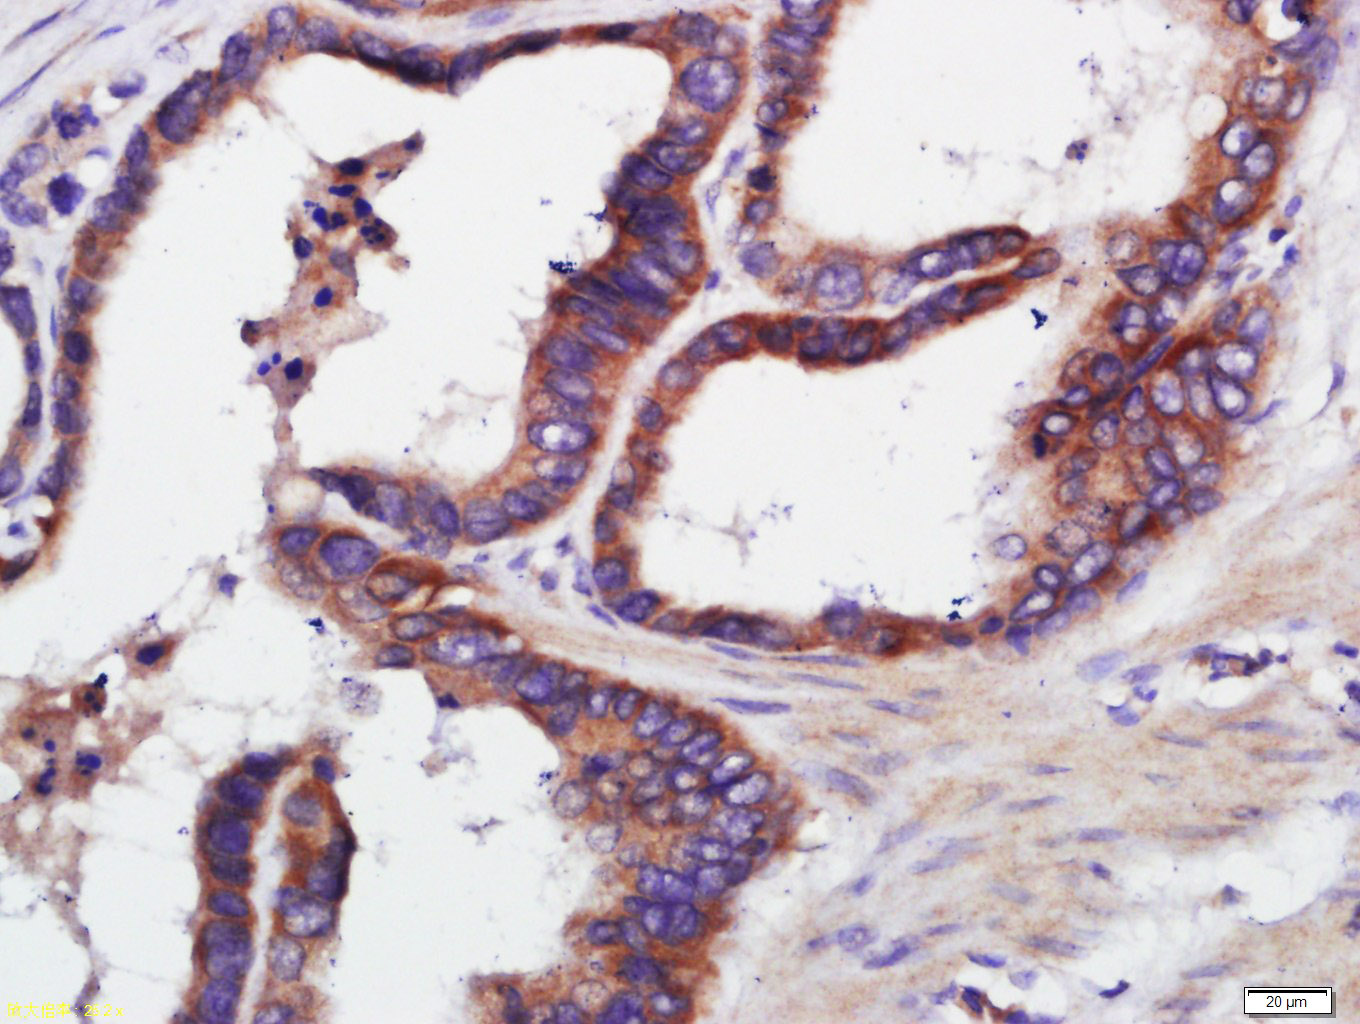
端粒酶反转录酶抗体-bs-0233R

TERT Rabbit pAb (一抗) - WB,IHC-P,IHC-F,IF,Flow-Cyt | Bioss

货号:bs-0233R
产品详情
相关标记
相关产品
相关文献
常见问题
概述
产品编号
bs-0233R
英文名称
TERT Rabbit pAb
中文名称
端粒酶反转录酶抗体
英文别名
CMM9; DKCA2; DKCB4; EST2; PFBMFT1; TCS1; TP2; TRT; hEST2; hTRT; TR; TERT_HUMAN; TERT; Telomerase catalytic subunit; Telomerase-associated protein 2 (TP2); 2.7.7.49; TERT_MOUSE; TERT_RAT;
抗体来源
Rabbit
免疫原
KLH conjugated synthetic peptide derived from human TERT: 601-750/1132
亚型
IgG
性状
Liquid
纯化方法
affinity purified by Protein A
克隆类型
Polyclonal
理论分子量
125 kDa
检测分子量
130 kDa
浓度
1mg/ml
储存液
0.01M TBS (pH7.4) with 1% BSA, 0.02% Proclin300 and 50% Glycerol.
研究领域
SWISS
Gene ID
保存条件
Shipped at 4℃. Store at -20℃ for one year. Avoid repeated freeze/thaw cycles.
注意事项
This product as supplied is intended for research use only, not for use in human, therapeutic or diagnostic applications.
数据库链接
产品介绍
端粒酶逆转录酶hTERT是构成端粒酶的组分之一,是端粒酶活性的必需和限速成分,水平决定细胞端粒酶的活性。抑制hTERT可降低端粒酶的活性,从而抑制瘤细胞生长。目前对hTERT的研究已成为端粒酶研究的热点问题,已发现TERT蛋白表达在肿瘤诊断中有重要意义,并制备了hTERT抗体及应用核酶技术等来抑制hTERT蛋白的表达,抑制端粒酶活性,从而抑制肿瘤的生长。
端粒反转录酶又称端粒酶催化亚单位 (hTRT;Telomerase catalytic subunit;HEST2;Telomerase-associated protein 2;TP2;Telomerase reverse transcriptase;telomerase catalytic subunit)是细胞永生化及恶性肿瘤发生过程中的端粒酶活化的主要限速步骤。hTRT基因表达可以反映端粒酶活性,与端粒酶活性具有平行关系。
端粒反转录酶又称端粒酶催化亚单位 (hTRT;Telomerase catalytic subunit;HEST2;Telomerase-associated protein 2;TP2;Telomerase reverse transcriptase;telomerase catalytic subunit)是细胞永生化及恶性肿瘤发生过程中的端粒酶活化的主要限速步骤。hTRT基因表达可以反映端粒酶活性,与端粒酶活性具有平行关系。
背景资料
Telomerase is a ribonucleoprotein polymerase that maintains telomere ends by addition of the telomere repeat TTAGGG. The enzyme consists of a protein component with reverse transcriptase activity, encoded by this gene, and an RNA component which serves as a template for the telomere repeat. Telomerase expression plays a role in cellular senescence, as it is normally repressed in postnatal somatic cells resulting in progressive shortening of telomeres. Deregulation of telomerase expression in somatic cells may be involved in oncogenesis. Studies in mouse suggest that telomerase also participates in chromosomal repair, since de novo synthesis of telomere repeats may occur at double-stranded breaks. Alternatively spliced variants encoding different isoforms of telomerase reverse transcriptase have been identified; the full-length sequence of some variants has not been determined. Alternative splicing at this locus is thought to be one mechanism of regulation of telomerase activity. [provided by RefSeq, Jul 2008].

产品应用
| 应用 | 已检合格种属 | 预测种属 | 推荐稀释比例 |
|---|---|---|---|
| WB | Human | Mouse, Rat | 1:500-2000 |
| IHC-P | Human, Mouse, Rat | 1:100-500 | |
| IHC-F | Human, Mouse, Rat | 1:100-500 | |
| IF | Human, Mouse, Rat | 1:100-500 | |
| Flow-Cyt | Human, Mouse | Rat | 1μg/Test |
交叉反应
交叉反应: Human, Mouse, Rat
相关产品
暂无相关产品
靶标
基因名
TERT
蛋白名
Telomerase reverse transcriptase
亚基
Homodimer; dimerization is required to produce a functional complex. Oligomer; can form oligomers in the absence of the telomerase RNA template component (TERC). Catalytic subunit of the telomerase holoenzyme complex composed minimally of TERT and TERC. The telomerase complex is composed of TERT, DKC1, WDR79/TCAB1, NOP10, NHP2, GAR1, TEP1, EST1A, POT1 and a telomerase RNA template component (TERC). The molecular chaperone HSP90/P23 complex is required for correct assembly and stabilization of the active telomerase. Interacts directly with HSP90A and PTGES3. Interacts with HSPA1A; the interaction occurs in the absence of TERC and dissociates once the complex has formed. Interacts with RAN; the interaction promotes nuclear export of TERT. Interacts with XPO1. Interacts with PTPN11; the interaction retains TERT in the nucleus. Interacts with NCL (via RRM1 and C-terminal RRM4/Arg/Gly-rich domains); the interaction is important for nucleolar localization of TERT. Interacts with SMARCA4 (via the bromodomain); the interaction regulates Wnt-mediated signaling. Interacts with MCRS1 (isoform MCRS2); the interaction inhibits in vitro telomerase activity. Interacts with PIF1; the interaction has no effect on the elongation activity of TERT. Interacts with PML; the interaction recruits TERT to PML bodies and inhibits telomerase activity.
亚细胞定位
Nucleus, nucleolus. Nucleus, nucleoplasm. Nucleus. Chromosome, telomere. Cytoplasm. Nucleus, PML body. Note=Shuttling between nuclear and cytoplasm depends on cell cycle, phosphorylation states, transformation and DNA damage. Diffuse localization in the nucleoplasm. Enriched in nucleoli of certain cell types. Translocated to the cytoplasm via nuclear pores in a CRM1/RAN-dependent manner involving oxidative stress-mediated phosphorylation at Tyr-707. Dephosphorylation at this site by SHP2 retains TERT in the nucleus. Translocated to the nucleus by phosphorylation by AKT.
组织特异性
Expressed at a high level in thymocyte subpopulations, at an intermediate level in tonsil T-lymphocytes, and at a low to undetectable level in peripheral blood T-lymphocytes.
翻译后修饰
Ubiquitinated, leading to proteasomal degradation.
Phosphorylation at Tyr-707 under oxidative stress leads to translocation of TERT to the cytoplasm and reduces its antiapoptotic activity. Dephosphorylated by SHP2/PTPN11 leading to nuclear retention. Phosphorylation by the AKT pathway promotes nuclear location.
Phosphorylation at Tyr-707 under oxidative stress leads to translocation of TERT to the cytoplasm and reduces its antiapoptotic activity. Dephosphorylated by SHP2/PTPN11 leading to nuclear retention. Phosphorylation by the AKT pathway promotes nuclear location.
疾病
Note=Activation of telomerase has been implicated in cell immortalization and cancer cell pathogenesis.
Defects in TERT are associated with susceptibilty to aplastic anemia (AA) [MIM:609135]. AA is a rare disease in which the reduction of the circulating blood cells results from damage to the stem cell pool in bone marrow. In most patients, the stem cell lesion is caused by an autoimmune attack. T-lymphocytes, activated by an endogenous or exogenous, and most often unknown antigenic stimulus, secrete cytokines, including IFN-gamma, which would in turn be able to suppress hematopoiesis.
Note=Genetic variations in TERT are associated with coronary artery disease (CAD).
Defects in TERT are the cause of dyskeratosis congenital autosomal dominant type 2 (DKCA2) [MIM:613989]. A rare multisystem disorder caused by defective telomere maintenance. It is characterized by progressive bone marrow failure, and the clinical triad of reticulated skin hyperpigmentation, nail dystrophy, and mucosal leukoplakia. Common but variable features include premature graying, aplastic anemia, low platelets, osteoporosis, pulmonary fibrosis, and liver fibrosis among others. Early mortality is often associated with bone marrow failure, infections, fatal pulmonary complications, or malignancy.
Defects in TERT are the cause of dyskeratosis congenital autosomal recessive type 4 (DKCB4) [MIM:613989]. A rare multisystem disorder caused by defective telomere maintenance. It is characterized by progressive bone marrow failure, and the clinical triad of reticulated skin hyperpigmentation, nail dystrophy, and mucosal leukoplakia. Common but variable features include premature graying, aplastic anemia, low platelets, osteoporosis, pulmonary fibrosis, and liver fibrosis among others. Early mortality is often associated with bone marrow failure, infections, fatal pulmonary complications, or malignancy.
Defects in TERT are a cause of susceptibility to pulmonary fibrosis idiopathic (IPF) [MIM:178500]. Pulmonary fibrosis is a lung disease characterized by shortness of breath, radiographically evident diffuse pulmonary infiltrates, and varying degrees of inflammation and fibrosis on biopsy. It results in acute lung injury with subsequent scarring and endstage lung disease.
Defects in TERT are associated with susceptibilty to aplastic anemia (AA) [MIM:609135]. AA is a rare disease in which the reduction of the circulating blood cells results from damage to the stem cell pool in bone marrow. In most patients, the stem cell lesion is caused by an autoimmune attack. T-lymphocytes, activated by an endogenous or exogenous, and most often unknown antigenic stimulus, secrete cytokines, including IFN-gamma, which would in turn be able to suppress hematopoiesis.
Note=Genetic variations in TERT are associated with coronary artery disease (CAD).
Defects in TERT are the cause of dyskeratosis congenital autosomal dominant type 2 (DKCA2) [MIM:613989]. A rare multisystem disorder caused by defective telomere maintenance. It is characterized by progressive bone marrow failure, and the clinical triad of reticulated skin hyperpigmentation, nail dystrophy, and mucosal leukoplakia. Common but variable features include premature graying, aplastic anemia, low platelets, osteoporosis, pulmonary fibrosis, and liver fibrosis among others. Early mortality is often associated with bone marrow failure, infections, fatal pulmonary complications, or malignancy.
Defects in TERT are the cause of dyskeratosis congenital autosomal recessive type 4 (DKCB4) [MIM:613989]. A rare multisystem disorder caused by defective telomere maintenance. It is characterized by progressive bone marrow failure, and the clinical triad of reticulated skin hyperpigmentation, nail dystrophy, and mucosal leukoplakia. Common but variable features include premature graying, aplastic anemia, low platelets, osteoporosis, pulmonary fibrosis, and liver fibrosis among others. Early mortality is often associated with bone marrow failure, infections, fatal pulmonary complications, or malignancy.
Defects in TERT are a cause of susceptibility to pulmonary fibrosis idiopathic (IPF) [MIM:178500]. Pulmonary fibrosis is a lung disease characterized by shortness of breath, radiographically evident diffuse pulmonary infiltrates, and varying degrees of inflammation and fibrosis on biopsy. It results in acute lung injury with subsequent scarring and endstage lung disease.
相似性
Belongs to the reverse transcriptase family. Telomerase subfamily.
Contains 1 reverse transcriptase domain.
Contains 1 reverse transcriptase domain.
功能
Telomerase is a ribonucleoprotein enzyme essential for the replication of chromosome termini in most eukaryotes. Active in progenitor and cancer cells. Inactive, or very low activity, in normal somatic cells. Catalytic component of the teleromerase holoenzyme complex whose main activity is the elongation of telomeres by acting as a reverse transcriptase that adds simple sequence repeats to chromosome ends by copying a template sequence within the RNA component of the enzyme. Catalyzes the RNA-dependent extension of 3'-chromosomal termini with the 6-nucleotide telomeric repeat unit, 5'-TTAGGG-3'. The catalytic cycle involves primer binding, primer extension and release of product once the template boundary has been reached or nascent product translocation followed by further extension. More active on substrates containing 2 or 3 telomeric repeats. Telomerase activity is regulated by a number of factors including telomerase complex-associated proteins, chaperones and polypeptide modifiers. Modulates Wnt signaling. Plays important roles in aging and antiapoptosis.
同靶标产品
相关文献
提示: 发表研究结果有使用 bs-0233R 时请让我们知道,以便我们可以引用参考文章。作为回馈,资料提供者将获得我们送上的小礼品。
具体参考文献:bs-0233R 被引用于24文献中